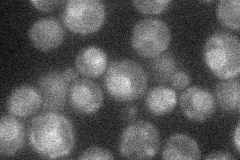
YJL091C
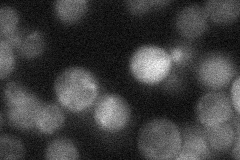
YJL091C
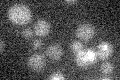
YJL091C

View description
Protein involved in the inositol acylation of glucosaminyl phosphatidylinositol (GlcN-PI) to form glucosaminyl(acyl)phosphatidylinositol (GlcN(acyl)PI), an intermediate in the biosynthesis of glycosylphosphatidylinositol (GPI) anchors
Localization:
Intensity:
Fold change:
Significance:
-
C’ GFP library in SD

below threshold14.05 -
N' NOP1pr-GFP in SD
ER18.6815 -
N' TEF2pr-mCherry in SD

below threshold9.46145 -
N' NATIVEpr-GFP in SD
punctate22.8857 -
N' TEF2pr-VC and Cyto-VN in SD

below threshold23.7712 -
C’ GFP library in SD+DTT

cytosol14.421.02No -
C’ GFP library in SD+H2O2

cytosol13.40.95No -
C’ GFP library in Starvation Media
cytosol14.591.03No -
C’ GFP library on the background of Pup2-DaMP

below threshold -
C’ GFP library on the background of CCT mutant

below threshold14.87051.05706No
